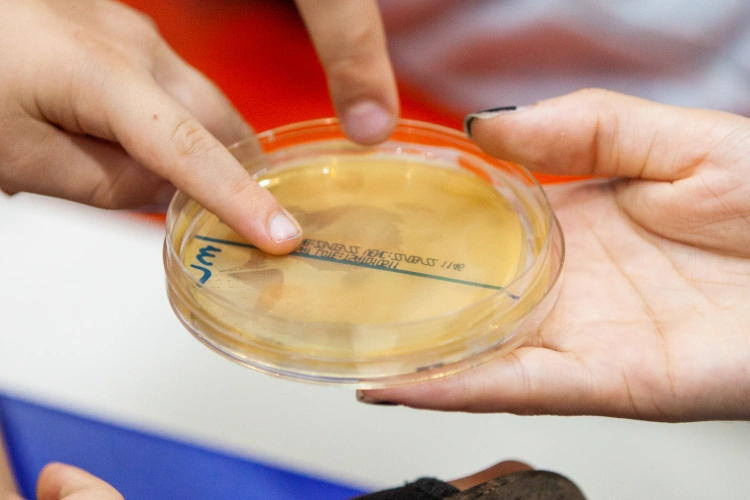
Crianças segurando placa de petri

Venha aprender como lavar as mãos corretamente para prevenir doenças infecciosas e aproveite para explorar o fascinante mundo dos animais que inspiram filmes de terror
Publicado em: 29/10/2025
Abrindo o mês de novembro ainda no clima do Dia das Bruxas, que tal desvendar os enigmas da história da vacinação? Os visitantes do Parque da Ciência Butantan também poderão conhecer alguns animais que marcaram cena em filmes de terror, além de aproveitar jogos temáticos no Museu da Vacina.
Confira a programação e participe!
Sexta Animal | Museu Biológico
Os visitantes são convidados a conhecer de perto alguns dos animais do Museu Biológico por meio de materiais educativos, além de poder conversar com os monitores sobre biodiversidade e conservação. A equipe também apresenta espécies e suas relações com a saúde humana e planetária.
Data: 31/10
Horário: 14h30
Local: Horto Oswaldo Cruz, com ponto de encontro no Museu Biológico
Vagas: 30
Inscrições: na recepção do Museu Biológico, a partir das 13h, até as vagas acabarem
Será que minhas mãos estão limpas? | Museu de Microbiologia Professor Isaias Raw
A lavagem adequada das mãos é uma atitude imprescindível para prevenir doenças infecciosas, tanto no nível individual quanto no coletivo. A atividade cumpre a missão de alertar os visitantes sobre essa importância e é livre para todos os públicos.
Data: sábado (1/11)
Horário: 10h30 e 14h30 (duas sessões)
Local: Museu de Microbiologia Professor Isaias Raw
Não é necessário se inscrever
Animais do museu: vilões do Halloween? | Museu Biológico
Os visitantes são convidados a explorar o mundo fascinante dos animais que inspiram filmes de terror – como serpentes, aranhas e escorpiões –, e conhecer de perto seus hábitos e sua importância em uma oficina de biscuit.
Data: sábado (1/11)
Horário: 15h
Local: miniauditório do Museu Biológico
Vagas: 20
Distribuição de senhas a partir das 13h, na recepção do Museu Biológico
Vacinação em Jogo – “Histórias Sombrias” | Museu da Vacina
A equipe educativa do museu vai disponibilizar jogos de tabuleiro e de cartas sobre vacinação e doenças imunopreveníveis. Além disso, os visitantes terão a oportunidade de conhecer o novo jogo “Histórias Sombrias: Vacinas e Doenças Evitáveis”, em que os jogadores devem desvendar enigmas sobre casos relacionados à história da vacinação e doenças preveníveis.
Data: sábado (1/11)
Horários: das 10h30 às 12h e das 14h às 16h
Local: Pátio interno do Museu da Vacina
Vagas: 20
Não é necessário se inscrever
As atividades podem ser alteradas ou canceladas sem aviso prévio.
Fique ligado na programação das próximas semanas de novembro: